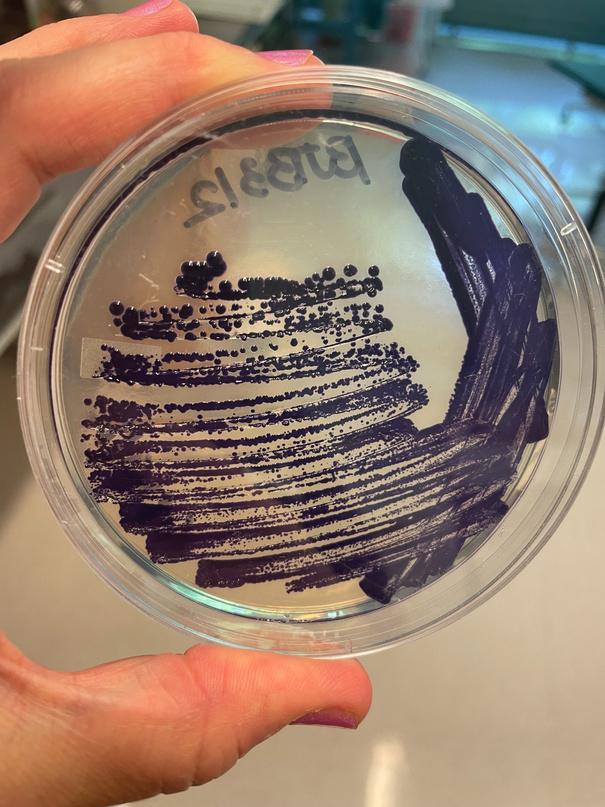

ﻲﻤﻴﻠﻗاﻮﻴﺑرﺎﻜﺘﺑإ ﺔﻴﺑوﺮﻜﻴﻤﻟاوﺔﻴﺗﺎﺒﻨﻟاﺔﻏﺎﺒﺼﻟا بﺮﻐﻤﻟا،حﻮﻠﻟاﻦﻴﻋ


2023 بﺮﻐﻤﻟا،حﻮﻠﻟاﻦﻴﻋ
،ﻦﻴﻌﺋاﺮﻟاﺎﻨﺋﺎﻛﺮﺸﻟﻼﻳﺰﺟاﺮﻜﺷ !ﻞﺒﻘﺘﺴﻣﱃإﻊﻠﻄﺘﻧ

دﺮﺠﻤﺑﻪﻧأﻰﺸﺧأ هﺬﻫتﻮﻤﺘﺳ،ﺎﻨﺗردﺎﻐﻣ نأﻰﻨﻤﺗأاﺬﻬﻟ .ﺔﻓﺮﺤﻟا اﺬﻫﻢﻠﻌﺘﻳ مﻮﻴﻟاتﺎﻴﺘﻔﻟا ،اﻮﻤﻠﻌﺗاذإ .ﻞﻤﻌﻟا ﺎﻤﻛةدﺎﻔﺘﺳﻻاﻦﻬﻨﻜﻤﻳ ﻦﺤﻧﺎﻧﺪﻔﺘﺳا... يﺮﻳودﺔﻴﻤﺷﺎﻬﻟا ﺔﻴﻧوﺎﻌﺘﻟاءﺎﺴﻧﺪﺣا
"Around The World in 80 Fabrics ﺔﺤﻨﻤﺑ
ءﺎﻤﻠﻌﻟاوﺞﻴﺴﻨﻟاءاﺮﺒﺧوﻦﻴﻤﻤﺼﻤﻟاوﻦﻴﺜﺣﺎﺒﻟاوﻦﻴﻳﺪﻴﻠﻘﺘﻟا ﺔﻴﻌﻴﺒﻃتﺎﻏﺎﺒﺻءﺎﺸﻧﻹلﺎﻤﻋﻷاتاﺪﺋاروﻦﻴﻴﺟﻮﻟﻮﺑوﺮﺜﻧﻷاو ٠بﺮﻐﻤﻟﺎﺑحﻮﻠﻟاﻦﻴﻋﺔﻘﻄﻨﻣﻲﻓتﺎﺑوﺮﻜﻴﻤﻟاوتﺎﺗﺎﺒﻨﻟاﻦﻣ فﻮﺼﻟاردﺎﺼﻣﻖﻴﺛﻮﺗو،ﻢﻨﻐﻟاةﺎﻋﺮﻟاﻊﻣتﻼﺑﺎﻘﻣءاﺮﺟإﻦﻣ ﺔﻴﺗﺎﺒﻨﻟاﺔﻴﻌﻴﺒﻄﻟاغﺎﺒﺻﻷافﺎﺸﻜﺘﺳاو،ﺎﻳوﺪﻳلوﺰﻐﻤﻟا

عوﺮﺸﻤﻟاﲆﻋ
"ضرﻷا "
ةردﺎﺒﻣلﻮﻤﺗ
ﻦﻴﺟﺎﺴﻨﻟاﻦﻴﺑﺎﻧوﺎﻌﺗدﻮﻘﺗﺚﻴﺣ،
ﻦﻣﺔﻣﺪﻘﻣ

تﺎﺟﻮﺴﻨﻤﻟاﲆﻋﺐﻠﻄﻟاةدﺎﻳزﱃإﺺﻴﺧﺮﻟاﻲﺑﺮﻐﻤﻟا ﺖﻗﻮﻟموﺪﺗﻻﻲﺘﻟاوﺎﻴﺋﺎﻴﻤﻴﻛﺔﺠﻟﺎﻌﻤﻟاوﺎﻴﻋﺎﻨﺻﺔﻏﻮﺒﺼﻤﻟا ﺔﻴﺌﻴﺒﻟاﻢﻈﻨﻟاﺔﺤﺻﲆﻋﺔﻴﺋﺎﻴﻤﻴﻜﻟاداﻮﻤﻟاهﺬﻫﺮﺛﺆﺗ
ﲆﻋﺮﻴﻏنﻮﻜﻠﻬﺘﺴﻤﻟاﻞﻈﻳﻦﻴﺣﻲﻓ،ﻦﻴﺟﺎﺴﻨﻟاوﺔﻴﻠﺤﻤﻟا .
ﻦﻣةﺪﻘﻌﻣﺔﻠﺴﻠﺳﻲﻓﻦﻤﺜﺑرﺪﻘﻳﻻﻂﺑارﻲﻫﺞﻴﺴﻨﻟاﺔﻓﺮﺣ ﻂﺑﺮﺗو،ﻊﻤﺘﺠﻤﻟاﻂﺑﺮﺗﻲﺘﻟاﺔﻤﻳﺪﻘﻟاﺔﻴﻓﺎﻘﺜﻟاتﺎﺳرﺎﻤﻤﻟا
ﺔﻠﺼﺘﻤﻟاﺔﻓﺮﻌﻤﻟاﻦﻣﺎﻧوﺮﻗﻦﻴﺟﺎﺴﻨﻟاﻦﻣﻦﺴﻣﻞﻴﺟﻞﻤﺤﻳ
ﻲﻓونﻵاﺔﺤﺻﺮﺜﻛﻷاﺔﻴﺌﻴﺒﻟاﻢﻈﻨﻟاﻢﻋﺪﻟةﺪﻳﺪﺟتارﺎﻜﺘﺑﻻ ؟ﻞﺒﻘﺘﺴﻤﻟا
Around The World in 80 Fabrics

(3) (ج) 501 ةدﺎﻤﻟاﺐﺟﻮﻤﺑﺔﻴﺤﺑرﺮﻴﻏﺔﻴﻤﻴﻠﻌﺗﺔﺴﺳﺆﻣﻲﻫ ناﻮﻟﻷاوفﺎﻴﻟﻷاﺔﺌﻴﺑوﻲﺟﻮﻟﻮﻴﺒﻟاعﻮﻨﺘﻟافﺎﺸﻜﺘﺳﺎﺑﺔﻣﺰﺘﻠﻣ
ﻦﻴﻌﻧﺎﺼﻟاتﺎﻌﻤﺘﺠﻤﺑلﺎﻔﺘﺣﻻاوﺔﻴﻌﻴﺒﻄﻟا تﺎﺟﻮﺴﻨﻤﻟاﻲﻌﻧﺎﺻضﺮﻋو،ىﻮﺘﺴﻣﻊﻓرو،ﻂﺑرو،ﻒﻴﻘﺜﺘﺑ ﻲﺘﻟاهﺎﻴﻤﻟاوﺔﺑﺮﺘﻟافاﺰﻨﺘﺳاﻦﻣﻻﺪﺑﺔﻳﺎﻋﺮﻟﺎﺑنﻮﻣﻮﻘﻳﻦﻳﺬﻟا

دﺎﺠﺴﻟاﻦﻣﻊﺒﺸﺗﻻﻲﺘﻟاﺔﻴﻤﻟﺎﻌﻟاقﻮﺴﻟاﺔﻴﻬﺷتد
.لﻮﻃأ
ﺔﻴﺌﻴﺒﻟاﺐﻗاﻮﻌﻟﺎﺑﻢﻠﻋ
ﻢﻬﺗﺎﻳﺮﺘﺸﻤﻟ
.تﻼﺋﺎﻌﻟاولﺰﻐﻟاعﺎﻨﺻومﺎﻨﻏﻷاةﺎﻋرووﻦﻴﻋراﺰﻤﻟاﻦﻴﺑ
ﻦﻓنوﺪﺑ .
ﲆﻋةرﺪﻗﻼﺑوﻞﻤﻋﻼﺑءﺎﺴﻨﻟاﻦﻣﺪﻳﺪﻌﻟانﻮﻜﺘﺳ،ﺞﻴﺴﻨﻟا .ﻦﻬﺗﻼﺋﺎﻋﻢﻋد
ﺔﻳﺎﻔﻜﻟاﻪﻴﻓﺎﻤﺑﺔﺳورﺪﻣﺮﻴﻏﻢﻬﺘﻓﺮﻌﻣو،ﻢﻬﺘﻓﺮﺤﺑ
ﻊﻠﻄﺘﻧﺎﻤﻨﻴﺑﺔﻘﺑﺎﺴﻟاﺔﻓﺮﻌﻤﻟاﱃإﺮﻈﻨﻧنأﺎﻨﻨﻜﻤﻳﻒﻴﻛ
ﺐﻛﻮﻜﻟااﺬﻫﲆﻋةﺎﻴﺤﻟالﺎﻜﺷأﻊﻴﻤﺟﻢﻋﺪﺗ
مﻮﻘﻧﻦﺤﻧ .


ARTISAN PROJECT ﺲﺳﺆﻤﻟا ﺪﻤﺤﻣ ﺎﻨﻴﻧ, هﺬﻫنﻮﻜﺘﺳ،ﻊﺳوأقﺎﻴﺳﻲﻓ سﺎﺳﻷاﻦﻣ،ﺮﻴﻴﻐﺘﻠﻟاﺰﻔﺤﻣ ﺔﻋﺎﻨﺻﻲﻓ،ﲆﻋﻷاﱃإ .دﺎﺠﺴﻟا

ﱃإباﺮﺘﻟاﻦﻣ
دﺎﺠﺴﻟا
.ﻲﺿرﻷاوﻲﺗﺎﻧاﻮﻴﺣﻊﻣﺔﻳﻮﻗﺔﻗﻼﻋﺎﻨﻳﺪﻟ ﻢﻬﺑﺎﻨﻴﻠﻋﷲﻢﻌﻧأ .نﻮﻠﻛﺄﻳ،ﻞﻛآﺎﻣﺪﻨﻋ ﻢﻬﻧإ .ﺪﻴﺟﻞﻜﺸﺑﻢﻬﺘﻳﺎﻋروﻢﻬﺘﻠﻣﺎﻌﻤﻟﻊﻨﺼﻣﺪﺟﻮﻳﻻ .ءﻲﺷﻞﻛﲆﻋنوﺮﺛﺆﻳ ﻞﺰﻴﻬﺠﺘﻟﻢﻳﺪﻗﻊﻨﺼﻣكﺎﻨﻫنﺎﻛنﻵا ﺒﻗ ﻪﻗﻼﻏإﻢﺗ .حﻮﻠﻟاﻦﻴﻋﻲﻓفﻮﺼﻟا 5) ﺎﺘﻨﺳ 50 ﻒﻠﻜﻳنﻷ.تاﻮﻨﺳ 4ء3
ﺎﻬﻌﻴﺑﻚﻨﻜﻤﻳﻻوﻢﻨﻏﺺﻘﻟ (ﻢﻫارد
ﻦﻣﺢﺑرﺪﺟﻮﻳﻻ .ﻢﻫارد 5 ـﺑىﻮﺳ

ﻻﺮﻬﻨﻟاﻲﻓفﻮﺼﻟاﻲﻘﻟأ
ﺲﻔﻧ
ﺔﺌﻴﻠﻣرﺎﻬﻧﻷاﻊﻴﻤﺟ .نﺎﻜﻣﻞﻛﻲﻓﻊﺿﻮﻟافﻮﺼﻟﺎﺑ. " . ﻲﻋار، ﷲﺪﻤﺣ ﻢﻳﺮﻛ حﻮﻠﻟا ﻦﻴﻋ ﺔﻘﻄﻨﻣ
ﻚﻟاﺬﻟ.فﻮﺼﻟا
.يدﺮﻔﻤﺑﺔﻣاﺪﺘﺳﻻاﻊﻴﻄﺘﺳأ

ﺮﻴﺜﻜﻟاكﺎﻨﻫنﺎﻛ،ةﺮﻴﻐﺻﺖﻨﻛﺎﻣﺪﻨﻋ


" هﺮﻴﺨﺒﺘﺑمﻮﻘﻧنأﺎﻨﻴﻠﻋنﺎﻛ .فﻮﺼﻟاﻦﻣ
ﺔﻊﻣلﺰﻨﻤﻟاﻲﻓفﻮﺼﻟايﺪﺗرأﺖﻨﻛ ﻴﻧوﺎﻌﺗكﺎﻨﻫﻦﻜﻳﻢﻟ .ناﺮﻴﺠﻟالﺎﻔﻃأ ﻻ،ﺮﺿﺎﺤﻟاﺖﻗﻮﻟاﻲﻓ .ﺖﻗﻮﻟاﻚﻟذﻲﻓ .نﻵاﺪﻌﺑفﻮﺼﻟالﺰﻐﺑءﺎﺴﻨﻟامﻮﻘﺗ ﺔﻴﻧوﺎﻌﺘﻟاءﺎﺴﻧﻦﻣ, حﻮﻠﻟاﻦﻴﻋ , كﺎﻜﺷوأﺔﺠﻳﺪﺧ
.ﻪﻄﻴﺸﻤﺗوﻪﻨﻣﻰﻘﺒﺗﺎﻣﺬﺧأوﻪﻠﺴﻏو
تﺎﻴﻤﻜﺑﺔﻴﻠﺤﻤﻟاقاﻮﺳﻷاﺎﻳوﺪﻳلوﺰﻐﻤﻟافﻮﺼﻟاﻦﻳﺰﻳﺎﻤﻨﻴﺑ ةﺮﻴﺒﻜﻟاتﺎﺒﻠﻄﻠﻟﺔﻴﻓﺎﻛﺔﻴﻤﻛﲆﻋلﻮﺼﺤﻟاﺢﺒﺼﻳ،ﺔﻌﺿاﻮﺘﻣ


.ﺔﻌﻔﺗﺮﻣﻒﻴﻟﺎﻜﺗوﺎﻗﺎﺷاﺪﻬﺟﺐﻠﻄﺘﺗﺔﺒﻌﺻﺔﻤﻬﻣ تﺎﻴﻧﺎﻄﺒﻟانﻮﻌﻨﺼﻳﻦﻳﺬﻟاﻦﻴﻴﻓﺮﺤﻟاﻲﺋﺎﻛﺮﺷددﺮﺘﻳ،ﻚﻟذ ﺎﻣﺪﻨﻋنددﺮﺘﻳ (دﺎﺠﺴﻟاﻦﻌﻨﺼﻳﻲﺗﻼﻟاءﺎﺴﻨﻟافﻼﺨﺑ
نﻮﻜﺗةﺮﻴﻌﺴﺗﻲﻋﺪﺘﺴﻳﺎﻤﻣ،ﺮﺴﻜﻟاﱃإيدﺆﺗﺪﻗﺎﻳوﺪﻳلوﺰﻐﻤﻟا ﺔﻟﻵاﺔﻄﺳاﻮﺑﺔﻟوﺰﻐﻤﻟاﺞﺴﻨﻟﺎﺑﺔﻧرﺎﻘﻣﻒﺼﻧوﺔﻔﻋﺎﻀﻣﺎﺒﻳﺮﻘﺗ
ﻞﻛ
ﺪﺣﻮﻤﻟاﻚﻤﺴﻟاوأنﻮﻠﻟﺎﺑﺪﻴﻘﻣﺮ .ﺐﻠﻘﻟاﺮﺳﺄﺗةﺪﻳﺮﻓ،ﻪﺑﺔﺻﺎﺧﺔﺼﻗﻞ ﺢﻨﻤﺗﺎﻤﻨﻴﺑﺎﻴﻟآلوﺰﻐﻤﻟافﻮﺼﻠﻟﻢﻠﺴ ﺎﻌﺑﺎﻃﻲﺗﺎﺟﻮﺴﻨﻣﺎﻳوﺪﻳﺔﻟوﺰﻐﻤ ؟ﺎﻤﻬﻟﻞﻴﺜﻣﻻ
ﻦﻋﺖﻔﺸﻛ،ﺔﻴﻠﺤﻤﻟاﺔﻴﻋﻮﺒﺳﻷاقا ﻻوﺪﻌﺗﻻﻲﺘﻟاناﻮﻟﻷاوﺔﺠﺴﻧﻷا .ﺎﻳوﺪﻳلوﺰﻐﻤﻟاﻲﻌﻴﺒﻄﻟافﻮﺼﻟاﻦ ﻊﺘﻤﺘﻳو،ﺔﻳﻮﻴﺤﻟﺎﺑﺲﻔﻨﺘﻳﻲﺤﻟاف
.
فﻮﺼﻟارﺪﺼﻣاذﺎﻤﻟ ؟ﻲﻌﻴﺒﻄﻟا
ﱃإﺔﻓﺎﺿﻹﺎﺑ
) ﺔﻴﻄﻏﻷاو فﻮﺼﻟاﺔﻌﻴﺒﻄﻓ .ﺎﻳوﺪﻳﺎﻬﻟﺰﻏﻢﺘﻳﻲﺘﻟافﺎﻴﻟﻷاﺔﺷﺎﺸﻫﻦﻬﺟاﻮﻳ
.
Artisan Project ﺔﺴﺳﺆﻣﺪﻤﺤﻣﺎﻨﻴﻧ
""

؟ﺔﻴﻋﺎﻨﻄﺻﻻاغﺎﺒﺻﻷا

ﺔﻴﺋﺎﻴﻤﻴﻛداﻮﻣﻦﻣﺔﻋﻮﻨﺼﻣﺔﻴﻋﺎﻨﻄﺻﻻاغﺎﺒﺻﻷا
ﻢﻈﻨﻟاﺮﻴﻣﺪﺗوبﺮﺸﻠﻟﺔﺤﻟﺎﺼﻟاهﺎﻴﻤﻟاﺚﻳﻮﻠﺗﱃإيدﺆﻳﺎﻤﻣ ﺔﻋارﺰﻟاﺔﻴﺟﺎﺘﻧإوﺔﺑﺮﺘﻟاةدﻮﺟرﻮﻫﺪﺗوﺎﻬﻠﻤﻛﺄﺑﺔﻴﺋﺎﻤﻟاﺔﻴﺟﻮﻟﻮﻜﻳﻹا.

ﻦﻋدﺎﻌﺘﺑﻻااذﺎﻤﻟ
Scholarly Community Encyclopedia :رﺪﺼﻤﻟا ﺎﻬﻧأﻲﻨﻌﻳاﺬﻫو،ﺔﻨﻃﺮﺴﻣﺮﺒﺘﻌﺗمﻮﻴﻟاﺔﻴﻋﺎﻨﻄﺻﻻاغﺎﺒﺻﻷاﻦﻣﺮﻴﺜﻛ غﺎﺒﺻﻷاقﻮﺤﺴﻣقﺎﺸﻨﺘﺳا .نﺎﻃﺮﺴﻟﺎﺑﺔﺑﺎﺻﻹاﻲﻓﺐﺒﺴﺘﺗﺪﻗ غﺎﺒﺻﻷﺎﺑهﺎﻴﻤﻟاﺚﻳﻮﻠﺗو،ﺲﻔﻨﺘﻟاﻞﻛﺎﺸﻣﺐﺒﺴﻳنأﻦﻜﻤﻳﺔﻣﺎﺴﻟا ﺔﻴﺤﺼﻟاﻞﻛﺎﺸﻤﻟاﻦﻣﺪﻳﺪﻌﻟﺎﺑﻂﺒﺗﺮﻳ. ﻊﻴﻤﺟﻲﻓﺎﻳﻮﻨﺳﺔﻴﻋﺎﻨﻄﺻﻻاغﺎﺒﺻﻷاﻦﻣﻦﻃ 700،000 جﺎﺘﻧإﻢﺘﻳ ،هﺎﻴﻤﻟايرﺎﺠﻣﻲﻓﺎﻬﻨﻣﻦﻃ
،000 قﻼﻃإﻢﺘﻳو،ﻢﻟﺎﻌﻟاءﺎﺤﻧأ
200
جﺎﺘﻧإﲆﻋﺎﻬﺗرﺪﻗﻦﻣﻢﻏﺮﻟاﲆﻋ .لوﺮﺘﺒﻟاﻦﻣﺔﻘﺘﺸﻣ صﺎﺨﺷﻷﺎﺑوﺔﺌﻴﺒﻟﺎﺑارﺮﺿﻖﺤﻠﺗﺎﻬﻧأﻻإ،ﺔﻘﺴﻨﺘﻣناﻮﻟأ .ﺔﻴﻠﻤﻌﻟاﻲﻓﺎﻬﻌﻣﻦﻴﻠﻣﺎﻌﻟا



ﻦﻣغﺎﺒﺻأ ﺔﻌﻴﺒﻄﻟا


تﺎﺑوﺮﻜ ﻤﻟا لﻮﺼﺤﻟاﺎﻨﻨﻜﻤﻳﻦﻳأ غﺎﺒﺻﻷاﲆﻋ ؟ﺔﻴﻌﻴﺒﻄﻟا Nردﺎﺼﻣ ﻦﻣ ناﻮﻟﻷا ﻦﻣ ﺔﻋﻮﻨﺘﻣ ﺔﻋﻮﻤﺠﻣ ﺮﻓﻮﺗ ﺔﻌﻴﺒﻄﻟا تﺎﺑوﺮﻜﻴﻤﻟاو ندﺎﻌﻤﻟاو تﺎﻧاﻮﻴﺤﻟاو تﺎﺗﺎﺒﻨﻟا .ﺔﺸﻫﺪﻣ فﺎﻴﻟﻸﻟ ﺔﻤﺋاد غﺎﺒﺻأ جﺎﺘﻧإ ﲆﻋ ةرﺪﻘﻟا ﺎﻬﻳﺪﻟ ﺎﻬﻌﻴﻤﺟ. غﺎﺒﺻﻸﻟ ﺔﺻﺎﺨﻟا ﺎﻫردﺎﺼﻣ ﺎﻬﻳﺪﻟ ﻢﻟﺎﻌﻟا ﻲﻓ ﺔﻘﻄﻨﻣ ﻞﻛ عاﻮﻧأ ﺐﺒﺴﺑ نﺎﻜﻣ ﻞﻛ ﻦﻣ ناﻮﻟﻷا ﻒﻠﺘﺨﺗ .ﺔﻴﻌﻴﺒﻄﻟا ،غﺎﺒﺻﻷا تﺎﻔﺻوو ،ﺔﻴﺌﻴﺒﻟا فوﺮﻈﻟاو ،غﺎﺒﺻﻷا ردﺎﺼﻣ ﺔﺣﻮﻟ ﺞﺘﻨﻳ ﻢﻟﺎﻌﻟا اﺬﻫ ﻲﻓ نﺎﻜﻣ ﻞﻛ .ﻚﻟذ ﻦﻣ ﺮﺜﻛأو ﻪﺑ ﺔﺻﺎﺧ ناﻮﻟأ. ...ناﻮﻟﻸﻟ ﻦﻳرﺪﺼﻣ ﱃإ ﺮﻈﻨﻧ ﻦﺤﻧ ،ﺎﻨﻋوﺮﺸﻤﻟ ﺔﺒﺴﻨﻟﺎﺑ تﺎﺗﺎﺒﻨﻟا

ﺔﻴﺑوﺮﻜﻴﻣغﺎﺒﺻأ

نﻮﻜﺗ ﺎﻣ ﺎﺒﻟﺎﻏ ،ﺔﻴﺣ تﺎﻨﺋﺎﻛ ﻲﻫ تﺎﺑوﺮﻜﻴﻤﻟا .ةدﺮﺠﻤﻟا ﻦﻴﻌﻟﺎﺑ ﺎﻬﺘﻳؤر ﻦﻜﻤﻳ ﻻ اﺪﺟ ةﺮﻴﻐﺻ ﺔﻴﻌﻴﺒﻃ غﺎﺒﺻأ جﺎﺘﻧإ ﲆﻋ ةردﺎﻗ عاﻮﻧﻷا هﺬﻫ ﺾﻌﺑ ﺎﻬﻨﻜﻤﻳ غﺎﺒﺻأ يأ ﺔﻳؤر ﻞﺟأ ﻦﻣ ﻦﻜﻟو .ﺔﻣاﺪﺘﺴﻣو ﻦﻣ تﺎﺑوﺮﻜﻴﻤﻟا هﺬﻫ ﺮﺛﺎﻜﺗ ﱃإ جﺎﺘﺤﻧ ،ﺎﻬﺟﺎﺘﻧإ ،ىﺮﺧﻷا ﺔﻳﺮﻬﺠﻤﻟا تﺎﻨﺋﺎﻜﻟا ﻦﻋ ﺎﻬﻠﺼﻓو ،ﺔﺌﻴﺒﻟا تاﺮﺒﺘﺨﻤﻟا ﻲﻓ ﺎﻬﻔﻴﺻﻮﺗو. ﺎﻘﺑﺎﺳ ﺎﻬﻓﺎﺸﺘﻛا ﻢﺘﻳ ﻢﻟ ﻲﺘﻟا تﺎﺑوﺮﻜﻴﻤﻟا عاﻮﻧأ ةﺪﻳﺪﺟ غﺎﺒﺻﻷ ارﺪﺼﻣ ﺎﻨﻟ مﺪﻘﺗ نأ ﻦﻜﻤﻳ ﺔﻣاﺪﺘﺴﻣو.
ﻦﻴﺳﻻﻮﻳﺎﻔﻟابوﺮﻜﻴﻣﻦﻣﻲﺠﺴﻔﻨﺒﻟانﻮﻠﻟاﺔﻐﺒﺻ



ﺔﻴﻔﻴﻛ هﺎﻧدأ ﻲﻧﺎﻴﺒﻟا ﻢﺳﺮﻟا ﺢﺿﻮﻳ ﺔﻴﺌﻴﺒﻟا ﻢﻈﻨﻟا ﻲﻓ نﻮﻠﻟا فﺎﺸﺘﻛا جﺎﺘﻧﻹ هﺮﻴﺨﺴﺗ ﻦﻜﻤﻳ ﻢﺛ ، ﺔﻴﻠﺤﻤﻟا .ﺔﻏﺎﺒﺼﻠﻟ غﺎﺒﺻأ
نأﻦﻜﻤﻳﻒﻴﻛ ﲆﻋﻞﺼﺤﺗ ﻦﻣناﻮﻟﻷا ؟تﺎﺑوﺮﻜﻴﻤﻟا
ﺔﻴﺑوﺮﻜﻴﻤﻟاناﻮﻟﻷاعﻮﻨﺗﲆﻋلﺎﺜﻣ
هﺬﻫﺪﻳﺪﺤﺗلﻼﺧﻦﻣ ﺎﻨﺋﻼﻣزﻊﻣﻞﻤﻌﻟاوتﺎﺑوﺮﻜﻴﻤﻟا

ﻂﻲﻓﺎﻫدﻮﺟونﺎﻤﻀﻟﻦﻴﻴﻠﺤﻤﻟا ﺑﺮﺑمﻮﻘﻧ،ﺔﻣﺎﻌﻟاتﺎﻋدﻮﺘﺴﻤﻟا .ﻲﺟﻮﻟﻮﻨﻜﺘﻟارﺎﻜﺘﺑﻻﺎﺑﻆﻔﺤﻟا
مﻮﻴﻟاﺎﻬﻌﻤﺠﻧﻲﺘﻟاتﺎﺑوﺮﻜﻴﻤﻟا

ﺔﺪﻗﺎﻬﻨﻜﻟو،ﺔﻤﻳﺪﻗتﺎﻨﺋﺎﻛﻲﻫ ﻴﻌﻴﺒﻄﻟاغﺎﺒﺻﻸﻟردﺎﺼﻣنﻮﻜﺗ
ﻞﺒﻘﺘﺴﻤﻟاﻲﻓ.




ﺔﻌﻣﺎﺟ ﻦﻣ بﺮﻐﻤﻟا ﻲﻓ ﻦﻴﻴﻤﻠﻌﻟا ﺎﻨﺋﻼﻣز ﻦﻣ ﻢﻋﺪﺑ ﺰﻛﺮﻤﻟاو سدﺎﺴﻟا ﺪﻤﺤﻣ ﺔﻌﻣﺎﺟو يﺪﻌﺴﻟا ﻚﻟﺎﻤﻟا ﺪﺒﻋ ﻦﻣ ﺎﻨﻘﻳﺮﻓ مﺎﻗ ،ﻲﻨﻘﺘﻟاو ﻲﻤﻠﻌﻟا ﺚﺤﺒﻠﻟ ﻲﻨﻃﻮﻟا تﺎﻳﻻﻮﻟا ﻲﻓ ﻦﻴﻤﻴﻘﻤﻟا ﺔﻘﻴﻗﺪﻟا ءﺎﻴﺣﻷا ءﺎﻤﻠﻋ ﻲﻓ هﺎﻴﻤﻟاو ﺔﺑﺮﺘﻟاو تﺎﺗﺎﺒﻨﻟا ﻦﻣ تﺎﻨﻴﻋ ﺬﺧﺄﺑ ةﺪﺤﺘﻤﻟا ﱃإ ﻻﻮﺻو ﺮﺤﺒﻟا ﺢﻄﺳ ﻦﻣ اءﺪﺑ ،بﺮﻐﻤﻟا لﺎﻤﺷ .ﺮﺘﻣ 2000 ﻦﻣ بﺮﻘﻳ ﺎﻣ ﻊﻔﺗﺮﺗ ﻖﻃﺎﻨﻣ يﺮﻴﺷﺎﺒﻄﻟا ﺮﻤﺣﻷا ﻦﻴﻄﻟا ﻦﻣ تﺎﻨﻴﻋ ﺎﻧﺬﺧأ ﺪﻘﻟ ،ﺔﻳﺮﻀﺤﻟا نﺪﻤﻟا ﺔﺑﺮﺗو مﺎﻨﻏﻷا ةﺎﻋر ﻦﻣ بﺮﻘﻟﺎﺑ رﺎﻬﻧﻷاو ﺔﻴﻠﺒﺠﻟا لواﺪﺠﻟا ﻦﻣ ﺔﻄﻗﺎﺴﺘﻤﻟا هﺎﻴﻤﻟاو ﻰﺘﺣ .ةﺮﻴﻐﺼﻟا عدﺎﻔﻀﻟﺎﺑ ﺔﺌﻴﻠﻤﻟا ﻚﻠﺗ ﻰﺘﺣ - ﺔﻳرﻮﻠﺒﻟا ءﺎﺤﻟو ﺮﺠﺸﻟا قاروأو رﻮﻫﺰﻟا ﻦﻣ تﺎﻨﻴﻋ ﺎﻧﺬﺧأ ﺎﻨﻧأ .ﺎﻴﻠﺤﻣ ﺔﻋورﺰﻤﻟا تﺎﺗﺎﺒﻨﻟا جرﺎﺧ تﺎﺑوﺮﻜﻴﻤﻟا ﻦﻋ ﺚﺤﺒﻟا ﻦﻤﻀﺘﻳ ﺎﻣ ﺎﺒﻟﺎﻏ تﻻوﺎﻃ ﲆﻋ . "ﺦﺒﻄﻤﻟا ﻢﻠﻋ" ﻦﻣ ﺮﻴﺜﻜﻟا ﺮﺒﺘﺨﻤﻟا تﺎﺑوﺮﻜﻴﻣ ﺔﻋارز ﺎﻨﻨﻜﻤﻳ ،ﺖﻗﺆﻣ "ﺮﺒﺘﺨﻣ" ﻲﻓ ﺔﻴﺟرﺎﺧ ﺎﻬﻳﺪﻟ ﻲﺘﻟا ﻚﻠﺗ رﺎﻴﺘﺧاو ،يﺮﺘﺑ حاﻮﻟأ ﲆﻋ ةﺪﻳﺮﻓ ﺔﻳدروو ﺔﻴﻟﺎﻘﺗﺮﺑو ءاﺮﻔﺻ غﺎﺒﺻأ جﺎﺘﻧإ ﲆﻋ ةرﺪﻘﻟا ﺔﻴﺑوﺮﻜﻴﻤﻟا عاﻮﻧﻷا هﺬﻫ ﻆﻔﺣ ﻚﻟذ ﺪﻌﺑ ﻦﻜﻤﻳ .ءاﺮﻀﺧو ﺮﺒﻛأ ﻞﻜﺸﺑ ﺎﻬﻓﺎﺸﻜﺘﺳاو بﺮﻐﻤﻟا ﻲﻓ مﺎﻋ عدﻮﺘﺴﻣ ﻲﻓ ﺮﻳﻮﻄﺘﻠﻟ ﺔﻠﺑﺎﻘﻟا غﺎﺒﺻﻷا ﻲﻓ ﺎﻬﻣاﺪﺨﺘﺳﻻ.
تﺎﺑوﺮﻜﻴﻤﻟاﻦﻋﺚﺤﺒﻟا ...غﺎﺒﺻﻸﻟﺔﺠﺘﻨﻤﻟا



ﺔﺠﺘﻨﻤﻟاتﺎﺑوﺮﻜﻴﻤﻟاﺾﻌﺑﺎﻨﻫ ﻰﺘﺣﺎﻫﺎﻨﻔﺸﺘﻛاﻲﺘﻟاتﺎﻐﺒﺼﻠﻟ ...نﻵا ﻦﻣتﺎﺑوﺮﻜﻴﻤﻟاﻒﻴﺻﻮﺗوﺔﻴﻤﻨﺗﻲﻓﺮﻤﺘﺴﻧ .ﺔﻣﺎﻌﻟاتﺎﻋدﻮﺘﺴﻤﻟاﻲﻓﺎﻬﻈﻔﺣنﺎﻤﻀﻟﺎﻨﺗﺎﻨﻴﻋ
تﺎﻔﺻو


ﺔﻤﻬﻣﺔﺘﺑﺎﺛةدﺎﻣﻲﻫﺖﻴﺒﺜﺘﻟاةدﺎﻣ ﻊﻣﻂﺑاﺮﺘﻟﺎﺑﺔﻴﺗﺎﺒﻨﻟاﺔﻐﺒﺼﻠﻟﺢﻤﺴﺗ .فﺎﻴﻟﻷا .ﺎﻘﺒﺴﻣ ﻚﻓﺎﻴﻟأ ﻂﺑﺮﺑ نﺎﺘﻴﻟﺎﺘﻟا نﺎﺘﻔﺻﻮﻟا ﻚﻟ ﺢﻤﺴﺗ ﺔﻴﺗﺎﺒﻨﻟا غﺎﺒﺻﻷا ﻞﻛ ﺖﺴﻴﻟ ﻪﻧأ ﺔﻈﺣﻼﻣ ﻰﺟﺮﻳ ﺔﻄﺑار ةدﺎﻣ ﺐﻠﻄﺘﺗ. ﻦﻣ ﺎﻣاﺮﺟ 150 مﺪﺨﺘﺳا ،فﺎﻴﻟﻷا ﻦﻣ ﻢﺠﻛ 1 ﻎﺒﺼﻟ بﻮﻛ 1/3 ،2 ماﺪﺨﺘﺳا لدﺎﻌﻳ اﺬﻫو) ﺔﻋذﻼﻟا ةدﺎﻤﻟا (تﺎﺳﺎﻴﻘﻟا ﻦﻣ :ﺔﻨﺧﺎﺴﻟا ﺖﻧادرﻮﻣ ﺔﻴﻠﻤﻋ 1)ﻦﺧﺎﺴﻟا ءﺎﻤﻟا ﻲﻓ ﺔﺒﺸﻟا ﻲﺑوذ. 2) ﺔﻴﻓﺎﻛ ﺔﻴﻤﻛ ﻪﺑ ءﺎﻋو ﱃإ ﺐﺸﻟاو فﺎﻴﻟﻷا ﻒﺿأ ﺔﻳﺮﺤﺑ كﺮﺤﺘﻟﺎﺑ فﺎﻴﻟﻸﻟ حﺎﻤﺴﻠﻟ ءﺎﻤﻟا ﻦﻣ. 3) ﺔﻋﺎﺳ ةﺪﻤﻟ نﺎﺧﺪﻟا ﺔﻄﻘﻧ ﺪﻨﻋ ﻦﻴﺨﺴﺘﻟﺎﺑ ﻢﻗ ةﺪﺣاو. :ﺪﻳﺪﺸﻟا دﺮﺒﻟا ﺔﻴﻠﻤﻋ 1) ﻦﺧﺎﺴﻟا ءﺎﻤﻟا ﻲﻓ ﺔﺒﺸﻟا ﺔﺑاذﺈﺑ ﻢﻗ. 2) ﺔﻴﻓﺎﻛ ﺔﻴﻤﻛ ﻪﺑ ءﺎﻋو ﱃإ ﺐﺸﻟاو فﺎﻴﻟﻷا ﻒﺿأ ﺔﻳﺮﺤﺑ كﺮﺤﺘﻟﺎﺑ فﺎﻴﻟﻸﻟ حﺎﻤﺴﻠﻟ ءﺎﻤﻟا ﻦﻣ. 3) ﻞﻛ ﺐﻠﻘﻳ .ﺔﻋﺎﺳ 24 ةﺪﻤﻟ ﺔﺒﺸﻟا مﺎﻤﺣ ﻲﻓ ﻪﻛﺮﺗا تﺎﻋﺎﺳ ﻊﻀﺑ.
ﺖﻧادرﻮﻣﺐﺸﻟا




حﻮﻟﻦﻴﻋﻲﻓﺔﻣﺎﻋﺔﻘﻳﺪﺣ :رﺪﺼﻤﻟ قاروﻷا :تﺎﺒﻨﻟاءﺰﺟ جزﺎﻃ .فﺎﺟ : ﺔﻐﺒﺼﻟاعﻮ ﺐﻠﺻ .قﻮﺤﺴﻣ دﻮﺳﻷازﻮﺠﻟاقاروأ Juglans nigra:ﻲﻤﻠﻌﻟاﻢﺳﻻا :ﺔﻔﺻو رﻮﻓرﺎﻛﺔﺒﻴﻘﺣﻒﺼﻧ :فﺎﻴﻟﻷاﺔﻴﻤﻛ ماﺮﻏﻮﻠﻴﻛ 1 :تﺎﺒﻨﻟاﺔﻴﻤﻛ ءﻲﺷﻻ :ندﺮﻤﻟاعﻮ ﻲﻓﻊﻘﻨﺗدﻮﺳﻷا ﻞﺒﻗﻞﻴﻠﻟا ﺮﻴﺨﺒﺘﻟاﺔﻄﻘﻧ أﺪﺒﻳﺎﻣﺪﻨﻋءﺎﻋﻮﻟاﻲ ﺪﻌﺑرﺎﻨﻟاﺊﻔﻃأﻢﺛر .ﻊﻘﻨﺗ ﻞﻴﻠﻟالاﻮﻃةﺪﺣاو ﺮﻀﺧأﺎﻧﻮﻟﺞﺘﻧأ


جزﺎﻃ .فﺎﺟ سﺎﻓقﻮﺳ:رﺪﺼﻤﻟا قاروﻷا :تﺎﺒﻨﻟاءﺰﺟ ءﺎﻨﺤﻟا Lawsonia inermis:ﻲﻤﻠﻌﻟاﻢﺳﻻا



حﻮﻟﻦﻴﻋقﻮﺳ :رﺪﺼﻤﻟا قاروﻷا :تﺎﺒﻨﻟاءﺰﺟ جزﺎﻃ .فﺎﺟ : ﺔﻐﺒﺼﻟاعﻮﻧ ﺐﻠﺻ .قﻮﺤﺴﻣ Lawsonia inermis:ﻲﻤﻠﻌﻟاﻢﺳﻻا :فﺎﻴﻟﻷاﺔﻴﻤﻛ ماﺮﻏﻮﻠﻴﻛ 1 :تﺎﺒ ءﺎﻨﺤﻟاقاروأ :ﺔﻔﺻو ءﻲﺷﻻ :ندﺮ :ﺔﻔﺻ ءﺎﻤﻟاﱃإءﺎﻨﺤﻟاقاروأﻒ .ﺔﻋﺎﺳةﺪﻤﻟ ﻲﻓﻊﻘﻨﺗﺎﻬﻛﺮﺗاوفﺎﻴﻟﻷاﻒ .ﻞﻴﻠﻟالاﻮﻃﺔﻐﺒﺼ





جزﺎﻃ .فﺎﺟ ﺐﻠﺻ قﻮﺤﺴﻣ حﻮﻟﻦﻴﻋﺔﻴﻌﻤﺟ :رﺪﺼﻤﻟا ءﺎﺤﻠﻟا :تﺎﺒﻨﻟاءﺰﺟ : ﺔﻐﺒﺼﻟاعﻮﻧ ﺮﻀﺧﻷاطﻮﻠﺒﻟاﺐﺸﺧ Quercus rotundifolia:ﻲﻤﻠﻌﻟاﻢﺳﻻا :ﺔﻔﺻو ماﺮﻏﻮﻠﻴﻛ 1 :فﺎﻴﻟﻷاﺔﻴﻤﻛ ماﺮﻏﻮﻠﻴﻛ 1 :تﺎﺒﻨﻟاﺔﻴﻤﻛ ءﻲﺷﻻ :ندﺮﻤﻟاعﻮﻧ 48 ةﺪﻤﻟ


:رﺪﺼﻤﻟا ﺔﺌﺴﻳﻮﺟ Galium
ﻲﻤﻠﻌﻟاﻢﺳﻻا ﻲﻠﺤﻣ
rotundifolium:



جزﺎﻃ .فﺎ ﺐﻠﺻ قﻮ سﺎﻓقﻮﺳ:رﺪﺼﻤﻟا ﻲﺗﺎﺒﻧءﺰﺟ : ﺔﻐﺒﺼﻟا ﺔﻴﻐﺒﺻةﻮﻓ Rubia peregrina:ﻲﻤﻠﻌﻟاﻢﺳﻻا : ماﺮﻏﻮﻠﻴﻛ 1 :فﺎﻴ ماﺮﻏ 130 :تﺎﺒ ﺐﺸﻟا :ةد :ﺔﻔﺻ مﺎﻤﺣﱃإﺰﻣﺮﻘﻟاﻒ ءﺎﻤﻟانﻮﻜﻳﺎﻣﺪﻨﻋﺔ .رﺎﺨﺒﻟاﺪﻋﺎﺼﺘﻳو ءﺎﻤﻟاﻲﻓتﺎﺒﻨﻟاﻊ .ﺔﻋﺎﺳةﺪﻤﻟﻦ ﻊﻘﻨﺗﺎﻬﻛﺮﺗاوفﺎﻴﻟﻷاﻒﺿ .ﻞﻴﻠﻟالاﻮﻃﺔﻐﺒﺼﻟامﺎﻤ
Punica granatum:ﻲﻤﻠﻌﻟاﻢﺳﻻا



سﺎﻓقﻮﺳ:رﺪﺼﻤﻟا
ﺔﻬﻛﺎﻔﻟاﺪﻠﺟ :تﺎﺒﻨﻟاءﺰﺟ
ماﺮﻏ 250 :تﺎﺒﻨﻟاﺔﻴﻤﻛ
ﺐﺸﻟا :ةدﺎﻤﻟاعﻮﻧ :ﺔﻔﺻﻮﻟاﺪﻌﺑ
ةﺪﻤﻟﻲﻠﻐﻣءﺎﻣﻲﻓتﺎﺒﻨﻟاﻊﻘﻨﻧ (1 ﺔﻋﺎﺳ
مﺎﻤﺣﻲﻓفﺎﻴﻟﻷاﻲﻌﻘﻧا (2 لاﻮﻃوأﻦﻴﺘﻋﺎﺳةﺪﻤﻟﺔﻐﺒﺼﻟا
ﺞﺋﺎﺘﻨﻟاﻞﻀﻓأﲆﻋلﻮﺼﺤﻠﻟﻞﻴﻠﻟا
ﻊﻣﻪﺟﺰﻣﺪﻨﻋاﺪﻴﺟﻞﻤﻌﻳ (3 .نﻮﻠﻟاﻞﻳﺪﻌﺘﻟىﺮﺧأتﺎﻐﺒﺻ
جزﺎﻃ فﺎﺟ : ﺔﻐﺒﺼﻟاعﻮﻧ ﺐﻠﺻ قﻮﺤﺴﻣ
نﺎﻣر
:ﺔﻔﺻو ماﺮﻏﻮﻠﻴﻛ 1 :فﺎﻴﻟﻷاﺔﻴﻤﻛ

Artisan Project Ain





ﺎﻴﺟﻮﻟﻮﺑوﺮﺜﻧﻷاﻢﻟﺎﻋوكرﺎﺸﻤﻟاﺲﺳﺆﻤﻟا،مﺎﻬﻧدلورﺎﻛ

ﺔﻘﻴﻗﺪﻟاءﺎﻴﺣﻷاﺔﻤﻟﺎﻋوﺲﺳﺆﻤﻟا،ندﺎﻣنآةرﻮﺘﻛﺪﻟا درﺎﺑﺔﻴﻠﻛ،كرﺎﺸﻣذﺎﺘﺳأ،دﻮﺟكوﺮﺑرﻮﺘﻛﺪﻟا LUMIX Ambassador ﺎﻨﻘﻳﺮﻓ
Leuh Cooperative
the World in 80 Fabrics The Microbe Institute بوﺮﻜﻴﻤﻟاﺪﻬﻌﻣ لﺎﺠﻣﻲﻓﻂﺷﺎﻧوكرﺎﺸﻣﺲﺳﺆﻣ،ﺲﻴﺛﻲﻧﺮﻴﺗرﻮﺘﻛﺪﻟا ﺔﻳﺮﺤﺒﻟاﺔﺌﻴﺒﻟاﲆﻋظﺎﻔﺤﻟا ﺞﻴﺴﻨﻟاﺔﻴﺋﺎﺼﺧأوﺔﻴﻋﻮﺘﻟاةﺮﻳﺪﻣ،نﻮﺴﺗﺮﺑورﻲﻟﺰﻴﻟ
ﺔﻴﺒﻄﻟا ﻲﻋاﺪﺑإةﺮﻳﺪﻣوﺔﺴﺳﺆﻣ,ﺪﻤﺤﻣﺎﻨﻴﻧ ﺔﻤﺟﺮﺘﻣوﺔﺑرﺪﺘﻣ,ﺮﻴﺒﻠﻏﺔﻧﻮﻤﻴﻣ ﺔﻤﺟﺮﺘﻣوﺔﺑرﺪﺘﻣ,ﺮﻴﺒﻠﻏﺔﻤﻴﻠﻋ كﺎﻴﺘﺴﺟﻮﻠﻟا,ﻲﺣﺎﻤﻟاﻦﺑايﺪﻬﻤﻟا ةﺪﻋﺎﺴﻣ,ﻲﻠﻋﺎﻴﺴﻟاﺔﻨﻴﻜﺳ ﺔﻴﻧوﺎﻌﺘﻟاﺔﺴﻴﺋر،يﺪﺒﻌﻟاﺔﺠﻳﺪﺟ قوﺪﻨﺼﻟاﻦﻴﻣأ،يﺮﻳودﺔﻴﻤﺷﺎﻬﻟا ةﺮﻴﺗﺮﻜﺳ،كﺎﻜﺷوجوﺪﺧ ﻲﺳوﺮﻌﻟاﺔﻤﻃﺎﻓ يواﺮﻤﻌﻟاﻮﺠﺣ ﻲﻓﺎﺴﻌﻟاةﺎﻴﺣ يﺪﻴﺷرﺔﻠﻴﻤﺟ ﺔﻠﺑواﺔﻳﺪﻌﺳ ﻢﻧﺎﻏةﺪﻴﺷر سﻮﺣﺎﺑﺔﻤﻬﻣ Jude Lab ﻲﻓاﺮﻏﻮﺗﻮﻓرﻮﺼﻣ،سوﺎﻫﻲﻤﻴﺟ
Around












ءﺎﺨﺳوﺔﺒﻫﻮﻤﻟﻖﻴﻤﻌﻟاﺎﻧﺮﻳﺪﻘﺗﻦﻋﺮﺒﻌﻧنأدﻮﻧ ﻪﺘﻗووهدراﻮﻤﺑﻢﻬﺳأيﺬﻟاﻪﻠﻤﻛﺄﺑﺎﻨﻘﻳﺮﻓﺔﻓﺮﻌﻣو
ءﺎﺴﻧﺔﻴﻧوﺎﻌﺗﻲﻓﻦﻴﺟﺎﺴﻨﻟاصﻮﺼﺨﻟﺎﺑﺮﻜﺸﻧنأدﻮﻧ ﻢﻬﻧﺎﻘﺗإوﻢﻬﺋﺎﺨﺳوﻢﻬﺘﺒﻫﻮﻤﺑﺎﻧوﺮﻬﺑأﻦﻳﺬﻟا،حﻮﻠﻟاﻦﻴﻋ

.ﺮﻤﺘﺴﻤﻟاعوﺮﺸﻤﻟااﺬﻫﻲﻓﻪﺘﻗﺎﻃو
ﺔﻠﻴﻤﺠﻟاﺔﻋﺎﻨﺼﻟاهﺬﻬﻟ. :ﺔﻴﻟﺎﺘﻟاتﺎﻤﻈﻨﻤﻟاوصﺎﺨﺷﻸﻟصﺎﺧﺮﻜﺷ :ضرﻷاﻞﺟأﻦﻣتﺎﻨﺑﺔﻤﻈﻨﻣﻦﻣﻢﻋﺪﻟا Panasonic ﻲﻨﻘﺘﻟاوﻲﻤﻠﻌﻟاﺚﺤﺒﻟاﺰﻛﺮﻣ،ﻲﻘﻓرقازﺮﻟاﺪﺒﻋ .ذﺎﺘﺳأ بﺮﻐﻤﻟا،(CNRST) ﺪﻤﺤﻣﺔﻌﻣﺎﺟ CNRST/UM6SS ،لاﺰﻏﻦﺴﺣرﻮﺴﻴﻓوﺮﺒﻟا ﺔﺤﺼﻟامﻮﻠﻋﻲﻓﺺﺼﺨﺘﻣسدﺎﺴﻟا ﺪﺒﻋﺔﻌﻣﺎﺟ / ﺔﺠﻨﻃ FST ﻲﻓلﺎﺠﻳرﺎﺑﺪﻴﻌﺳرﻮﺴﻴﻓوﺮﺒﻟا .(ةﺪﺤﺘﻤﻟاﺔﻴﺑﺮﻌﻟاتارﺎﻣﻹا) يﺪﻌﺴﻟاﻚﻟﺎﻤﻟا بوﺮﻜﻴﻤﻟاﺪﻬﻌﻣ درﺎﺑﺔﻴﻠﻛﻲﻓبﻻدﻮﺟ وﺎﺒﺸﻨﻴﻠﻓﺲﻳﺮﻏ،ATW80F ﺔﺑرﺪﺘﻣ


2023